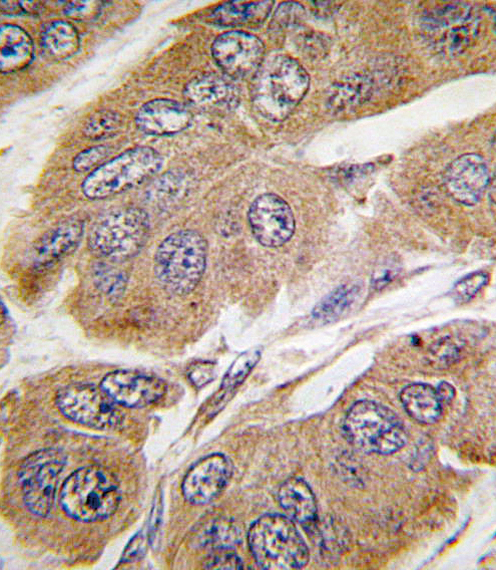

> Antigen, Antibodies, ELISA, Western Blot > Primary Antibody > Polyclonal Antibodies > S6K (RPS6KB1) Antibody (S424)Brand |
Leading Biology | Catalog Number |
AMR09804G |
Product Type |
Polyclonal Antibodies | Field of Research |
|
Product Overview |
We constantly strive to ensure we provide our customers with the best antibodies. As a result of this work we offer this antibody in purified format.
We are in the process of updating our datasheets. If you have any questions regarding this update, please feel free to contact our technical support team.
This product is a high quality S6K (RPS6KB1) antibody (S424).
|
||
Molecular Weight |
59140 Da
|
||
Cellular Localization |
Antigen Cellular Localization:
Cell junction, synapse, synaptosome. Mitochondrion outer membrane. Mitochondrion Note=Colocalizes with URI1 at mitochondrion Isoform Alpha II: Cytoplasm.
|
||
Host |
Rabbit
|
||
Species Reactivity |
Human
|
||
Immunogen |
425-454 aa
|
||
Target |
This S6K (RPS6KB1) antibody is generated from rabbits immunized with a KLH conjugated synthetic peptide between 425-454 amino acids from human S6K (RPS6KB1).
|
||
Isotype |
Rabbit Ig
|
||
Symbol |
STK14A
|
||
GeneID |
|||
UniProt ID |
|||
Function |
Serine/threonine-protein kinase that acts downstream of mTOR signaling in response to growth factors and nutrients to promote cell proliferation, cell growth and cell cycle progression. Regulates protein synthesis through phosphorylation of EIF4B, RPS6 and EEF2K, and contributes to cell survival by repressing the pro-apoptotic function of BAD. Under conditions of nutrient depletion, the inactive form associates with the EIF3 translation initiation complex. Upon mitogenic stimulation, phosphorylation by the mammalian target of rapamycin complex 1 (mTORC1) leads to dissociation from the EIF3 complex and activation. The active form then phosphorylates and activates several substrates in the pre-initiation complex, including the EIF2B complex and the cap-binding complex component EIF4B. Also controls translation initiation by phosphorylating a negative regulator of EIF4A, PDCD4, targeting it for ubiquitination and subsequent proteolysis. Promotes initiation of the pioneer round of protein synthesis by phosphorylating POLDIP3/SKAR. In response to IGF1, activates translation elongation by phosphorylating EEF2 kinase (EEF2K), which leads to its inhibition and thus activation of EEF2. Also plays a role in feedback regulation of mTORC2 by mTORC1 by phosphorylating RICTOR, resulting in the inhibition of mTORC2 and AKT1 signaling. Mediates cell survival by phosphorylating the pro-apoptotic protein BAD and suppressing its pro-apoptotic function. Phosphorylates mitochondrial URI1 leading to dissociation of a URI1-PPP1CC complex. The free mitochondrial PPP1CC can then dephosphorylate RPS6KB1 at Thr-412, which is proposed to be a negative feedback mechanism for the RPS6KB1 anti- apoptotic function. Mediates TNF-alpha-induced insulin resistance by phosphorylating IRS1 at multiple serine residues, resulting in accelerated degradation of IRS1. In cells lacking functional TSC1- 2 complex, constitutively phosphorylates and inhibits GSK3B. May be involved in cytoskeletal rearrangement through binding to neurabin. Phosphorylates and activates the pyrimidine biosynthesis enzyme CAD, downstream of MTOR.
|
||
Summary |
RPS6KB1 is a member of the RSK (ribosomal S6 kinase) family of serine/threonine kinases. This kinase contains 2 non-identical kinase catalytic domains and phosphorylates several residues of the S6 ribosomal protein. The kinase activity of this protein leads to an increase in protein synthesis and cell proliferation. Amplification of the region of DNA encoding the gene for RPS6KB1 and overexpression of this kinase are seen in some breast cancer cell lines.
|
||
Form |
Purified polyclonal antibody supplied in PBS with 0.09% (W/V) sodium azide. This antibody is purified through a protein A column, followed by peptide affinity purification. |
||
Storage & Stability |
Store at +4°C short term. For long-term storage, aliquot and store at -20°C or below. Stable for 12 months at -20°C. Avoid repeated freeze-thaw cycles.
|
||
Applications |
WB, IHC-P, E
|
||
Dilution |
WB~~1:1000
IHC-P~~1:10~50
|
||
Synonyms |
Ribosomal protein S6 kinase beta-1, S6K-beta-1, S6K1, 70 kDa ribosomal protein S6 kinase 1, P70S6K1, p70-S6K 1, Ribosomal protein S6 kinase I, Serine/threonine-protein kinase 14A, p70 ribosomal S6 kinase alpha, p70 S6 kinase alpha, p70 S6K-alpha, p70 S6KA, RPS6KB1, STK14A
|
||
Images |

Western blot analysis of RPS6KB1 (arrow) using rabbit polyclonal RPS6KB1 Antibody (S424) (RB11404). 293 cell lysates (2 ug/lane) either nontransfected (Lane 1) or transiently transfected with the RPS6KB1 gene (Lane 2) (Origene Technologies). ) 
Western blot analysis of Phospho-RPS6KB1-pS424 Antibody (AP3352a) and RPS6KB1 Antibody (S424) (AMR09804G) in human TNF alpha activated Hela cell line lysates. RPS6KB1 and Phospho-RPS6KB1 (arrow) was detected using the purified PAb. (lane 1: without TNF alpha; lane 2: TNF alpha activated, Phospho-RPS6KB1-pS424 Antibody (AP3352a); lane 3: TNF alpha activated, RPS6KB1 Antibody (S424) (AMR09804G)
Formalin-fixed and paraffin-embedded human breast carcinoma tissue reacted with RPS6KB1 Antibody (T421) (Cat. AMR09804G), which was peroxidase-conjugated to the secondary antibody, followed by DAB staining. This data demonstrates the use of this antibody for immunohistochemistry; clinical relevance has not been evaluated. |
||
Specification |
|||
Quantity |
|
||
| Select | Brand | Catalog No. | Product Name | Pack Size | Type | Field of Research | Specification | Quantity | Price(USD) | |
| 1 | Leading Biology | APR03440G | ITGA11 Antibody (N-term) | 100 μl | Polyclonal Antibodies |
|
$495.00 | Add Ask | ||
| 2 | Leading Biology | APR04537G | CMIP Antibody (C-term) | 100 μl | Polyclonal Antibodies |
|
$495.00 | Add Ask | ||
| 3 | Leading Biology | APR12422G | Human H4 Histamine Receptor (extracellular) Antibody | 50 μl | Polyclonal Antibodies |
|
$695.00 | Add Ask | ||
| 4 | Leading Biology | APR03844G | UBE2W Antibody (C-term) | 100 μl | Polyclonal Antibodies |
|
$495.00 | Add Ask | ||
| 5 | Leading Biology | APR04349G | HECTD2 Antibody (N-term) | 100 μl | Polyclonal Antibodies |
|
$495.00 | Add Ask | ||
| 6 | Leading Biology | APR03502G | IGHG1 Antibody (Center) | 100 μl | Polyclonal Antibodies |
|
$495.00 | Add Ask |
 Leading Biology Inc.
2600 Hilltop DR, Building G, B Suite C138
Richmond, CA, 94806
Tel: 1-661-524(LBI)-0262
Email: info@leadingbiology.com
Leading Biology Inc.
2600 Hilltop DR, Building G, B Suite C138
Richmond, CA, 94806
Tel: 1-661-524(LBI)-0262
Email: info@leadingbiology.com
Complete this form and click send to ask us a question, request a quote or simply say hello.

You have 0 item in your cart

You have 0 item in your inquiry list
